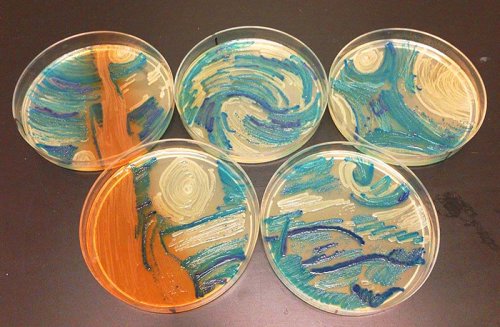

Дорогой друг, рекомендуем
войти на сайт под своим логином, либо авторизоваться через свою соцсеть.
Авторизация займет буквально два клика, и затем вы получите много возможностей на сайте, кроме того случится магия с уменьшением количества рекламы. Попробуйте, вам понравится!
Авторизоваться через:
Информация
Посетители, находящиеся в группе
Гости, не могут оставлять комментарии к данной публикации.